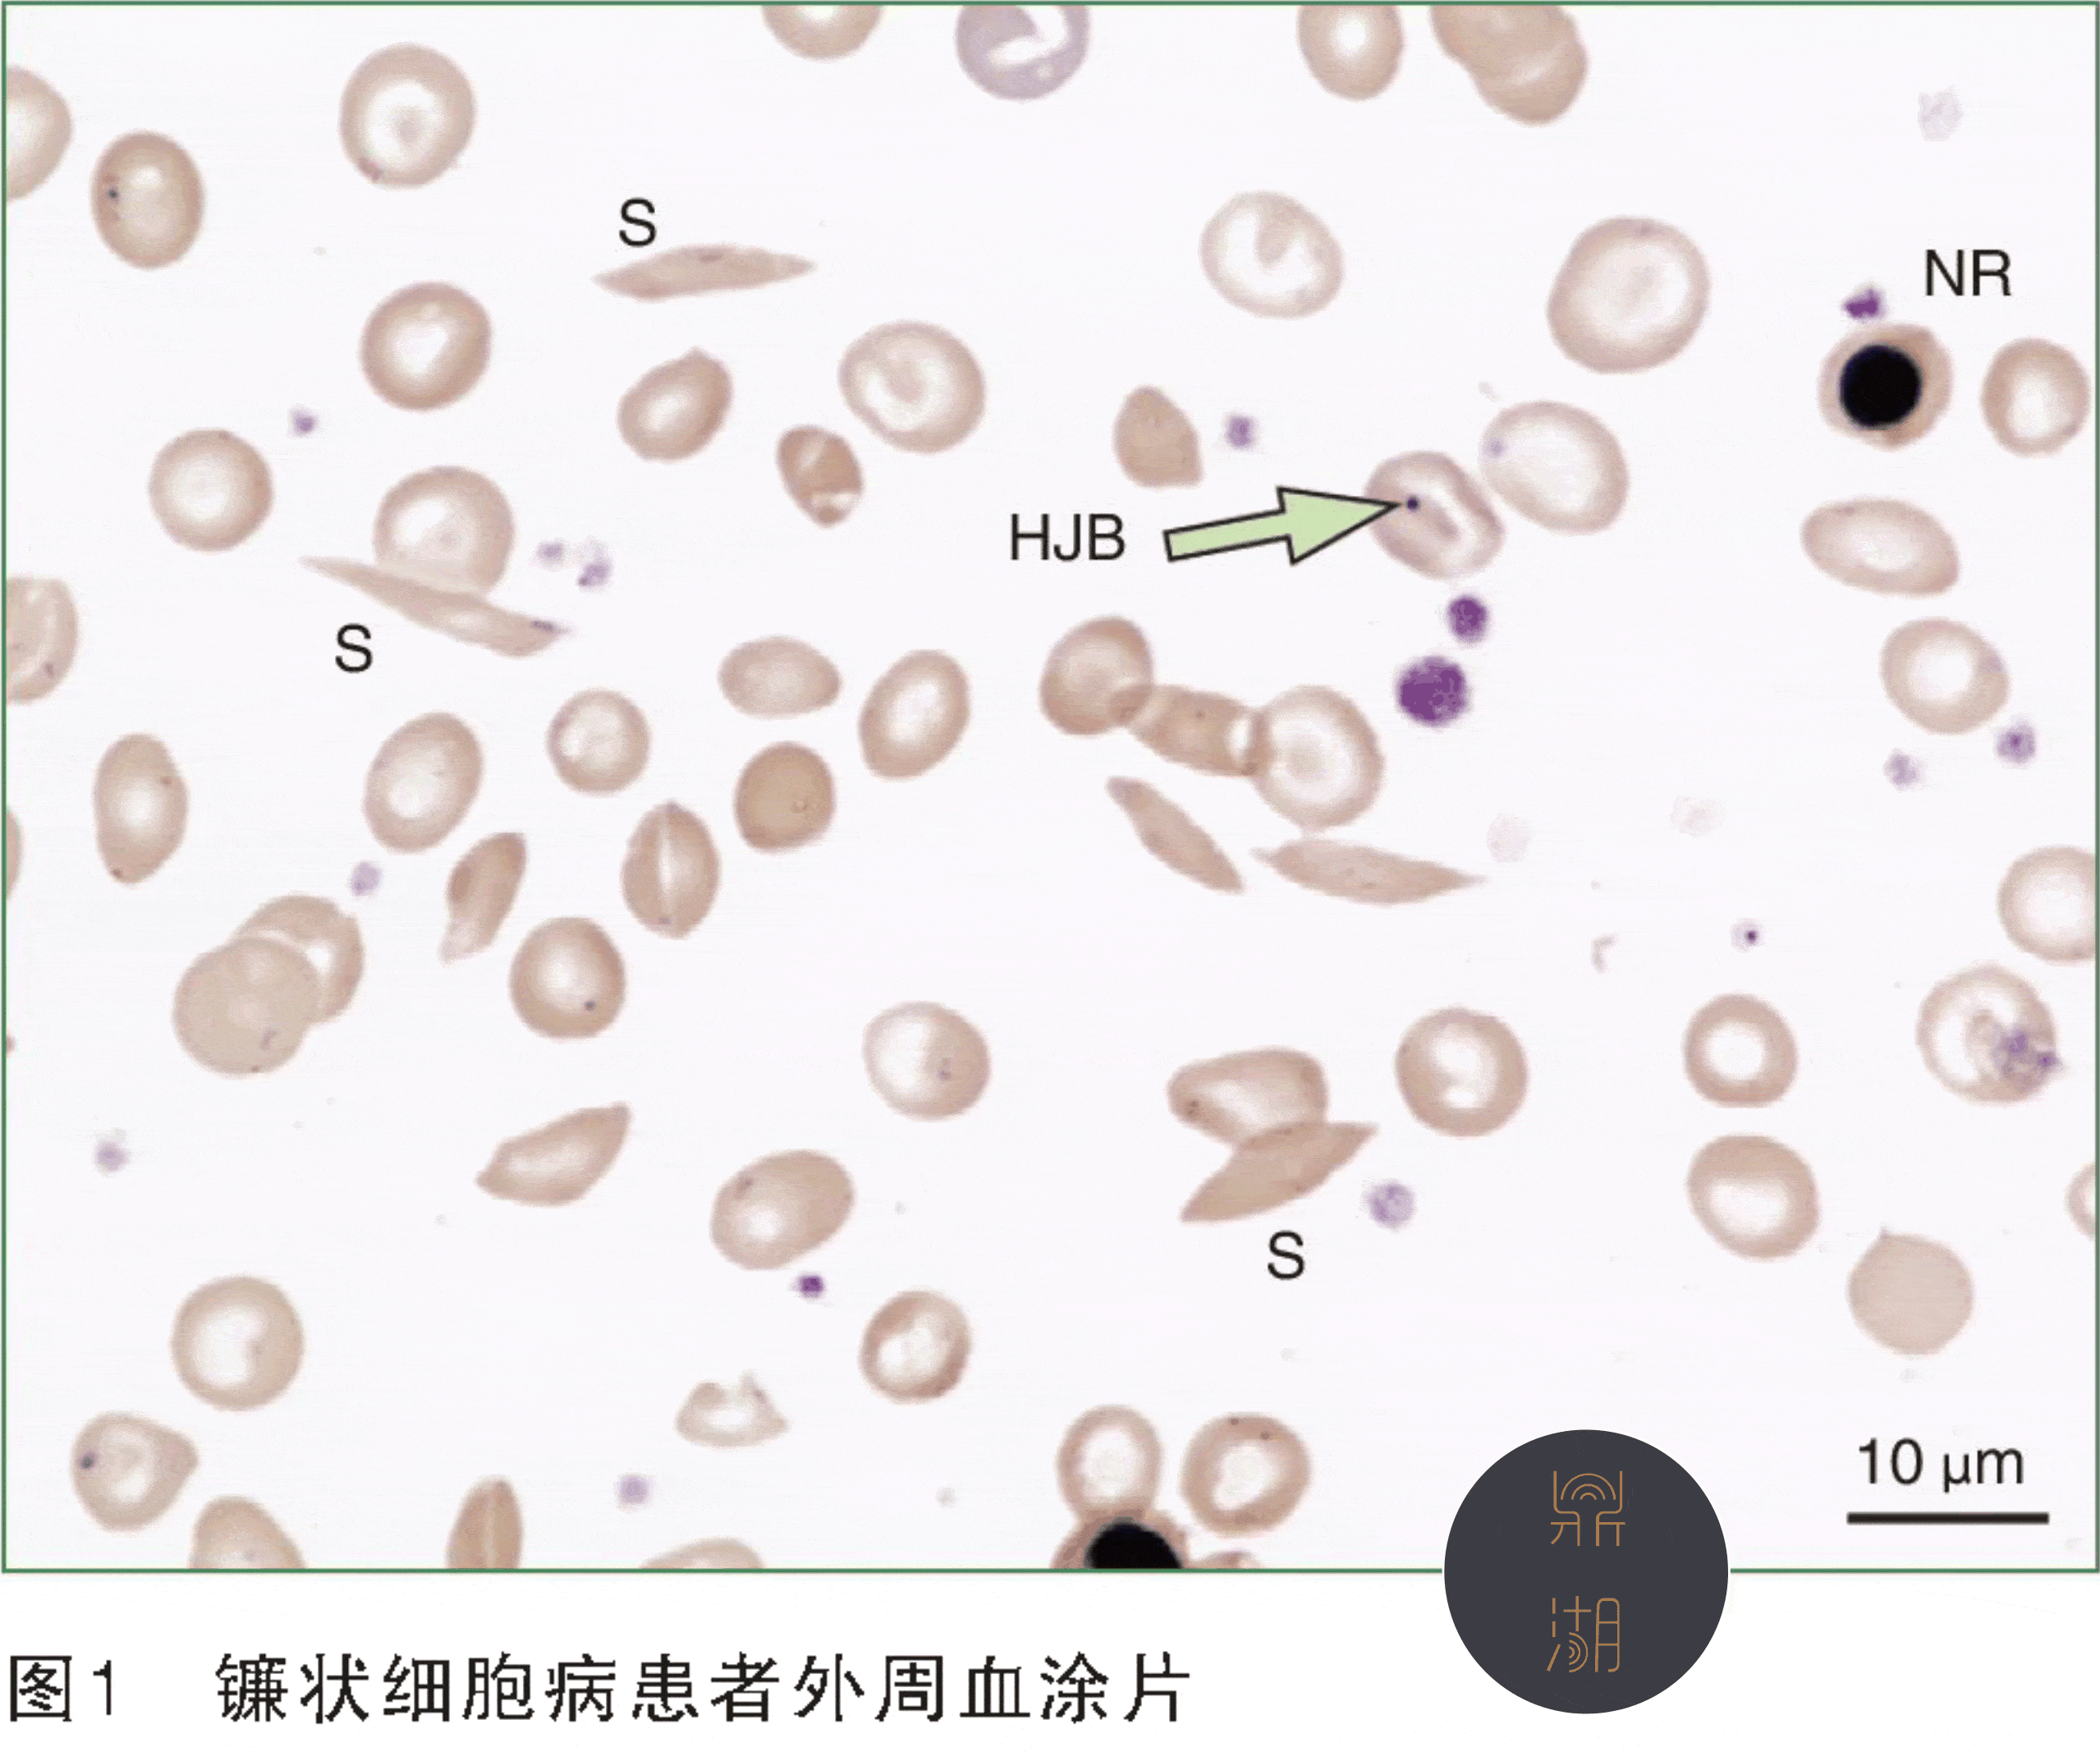
涨见识了,这种形态的椎体提示贫血_镰状_细胞_包括

高雪氏细胞

2,在急性感染期数周后,可出现一过性单核细胞mon增多,此时可能与流感
图片尺寸1748x1523
crispr use in humans shows promise while experts
图片尺寸827x620
之前养df-1细胞,细胞题壁但是不长,时间长了就慢慢飘起来了,取培养液
图片尺寸3120x4160
高雪氏症
图片尺寸371x300
一份高白细胞病例,我们一起来读片吧
图片尺寸2000x2038
451.请识别箭头所指的细胞(骨髓10x100倍,瑞吉染色)
图片尺寸1280x960
nci-h1563胚肺细胞株培养方法及生长特性_细胞培养有秘招的博客-csdn
图片尺寸2592x1944
涨见识了,这种形态的椎体提示贫血_镰状_细胞_包括
图片尺寸2558x2134
一份高白细胞病例,我们一起来读片吧
图片尺寸2505x2000
白细胞低多少是白血病,恢复血小板最好的方法(全血细胞减少到白血病
图片尺寸640x636
中性粒细胞偏低是什么意思(中性粒细胞偏低的网络用语是什么梗)-图4
图片尺寸700x490
服务流程客户提供● 生长期活跃的哺乳动物原代细胞或细胞系(无
图片尺寸2560x1920
万能的丁香园友,请问这个sw620细胞是怎么了?复苏后越来越差.
图片尺寸2368x4208
一份高白细胞病例,我们一起来读片吧
图片尺寸2000x2292
isolationandpurificationofschwanncellsfromspinalnerveso
图片尺寸1772x992
怎么画光镜下血液的图片
图片尺寸600x400
a549细胞状态总是不好,最近细胞出现一些双球菌样的亮点,这是污染吗?
图片尺寸3488x2880
1700人雪旺细胞-sciencell原代细胞
图片尺寸800x600
rsc96(大鼠雪旺细胞)
图片尺寸800x800
图313.请指出箭头所示的细胞名称(骨髓,瑞氏染色,10x100)
图片尺寸1199x1199